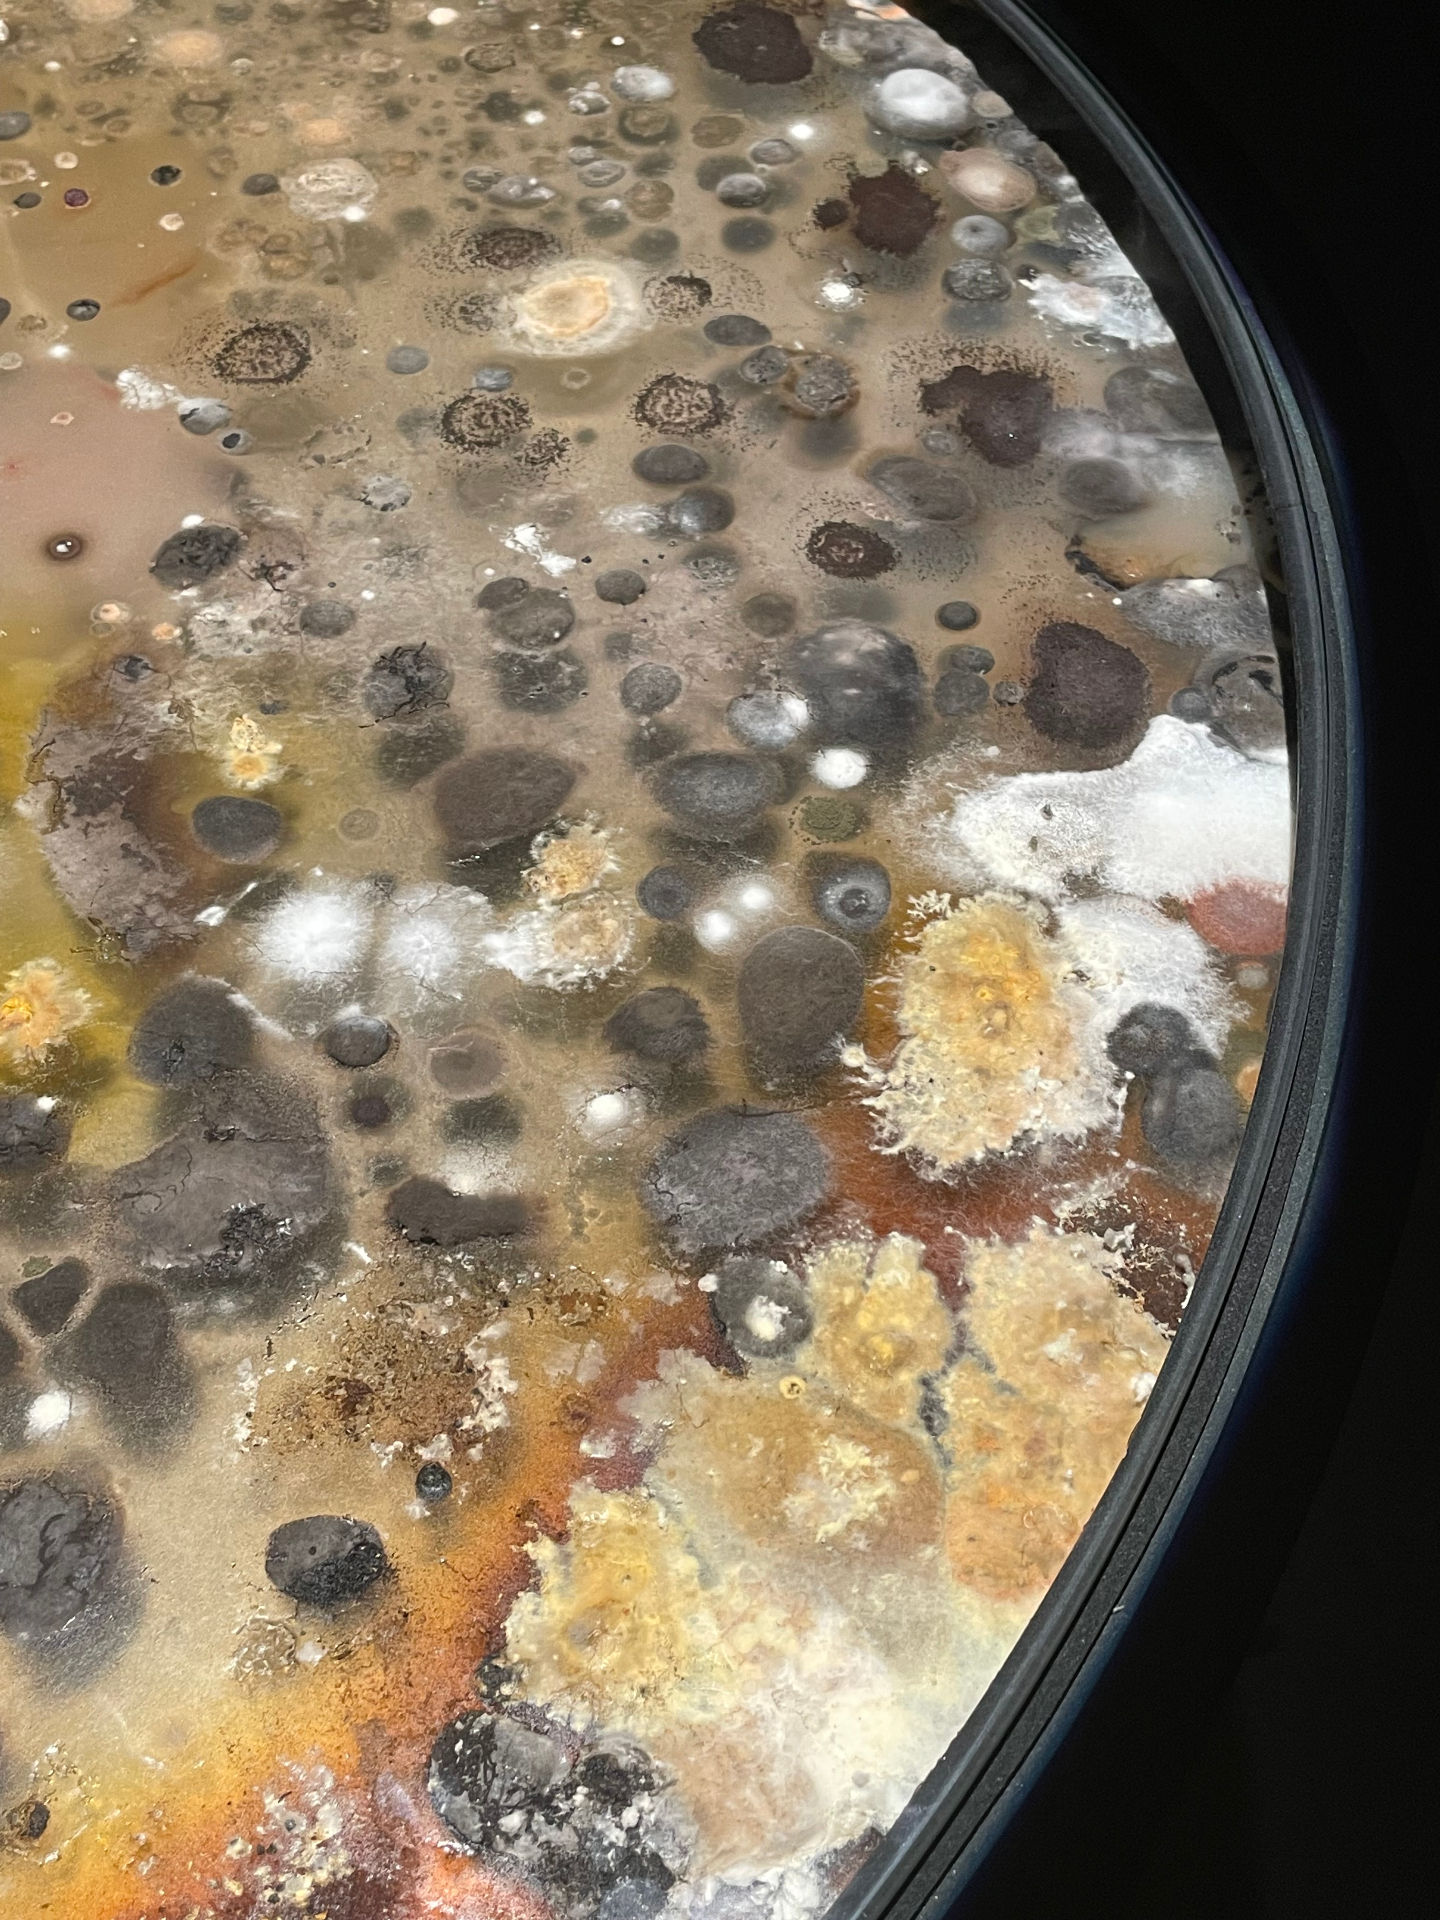
Venise 5

Die XXVI. Aprilis
MMXXIII
26.04.2023
Kunsthistorisches Museum, Vienna
Georg Baselitz — Towel - Beach Picture 6, 1980:
'The problem is not the object in the picture, but the picture as an object.' Simple, raw compositions in oil and egg tempera. Fierce, brusque pictures made alongside first sculptures. Enormous, unwieldy plasticity — but gaiety, occasionally comedy.
Mania, 2019:
Hands are an important motif. The hand of rulers, the hand of God. Blessing or damning, acting in isolation from golden ground. Later, Dürer and Parmigianino depicted their own hands to reassure themselves of their artistry.
Surrealism Is Moving, 2019:
'I paint a picture and I counterproof it. The counterproof is simply the lighter rendition, like a reflection. Just the illusion of it all.'
The Ice Skating Woman, 2019:
The canvas as an arena. Baselitz confidently plays with the method but does not relinquish the object. We are not looking at an ice skater floating across the lake at all — our entire vision begins to float.
Between Nature and Art:
Flowers and Fruits
Botanical knowledge increased continually during the 15th and 16th centuries. Local flora was systematically investigated and new species reached Europe from distant lands. Detailed illustrations accompanied scientific publications on herbs and plants, which artisans could use for accurate replicas of flowers and fruits in silver, glass, stone or ivory.
Bill Frisell and Thomas Morgan — Vienna playlist: Misterioso. Mumbo Jumbo. It Should Have Happened a Long Time Ago. You Only Live Twice. Goldfinger.